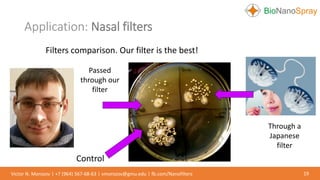
Application: Nasal filters
19Victor N. Morozov | +7 (964) 567-68-63 | vmorozov@gmu.edu | fb.com/Nanofilters
Filters comparison. Our filter is the best!
Through a
Japanese
filter
Passed
through our
filter
Control

The document describes a novel nanofilter developed by Victor N. Morozov's laboratory, which features a pore size of approximately 100 nm and boasts high optical transparency and low mass density, making it suitable for various biomedical and technical applications. The filters are fabricated from a range of polymer materials, exhibit superior filtration efficiency and low resistance to airflow compared to conventional HEPA filters, and have potential uses in medical diagnostics and protection against airborne pathogens. The document also discusses production efficiency, cost analysis, and potential applications including nasal filters, air quality monitoring, and electronic device protection.












![Comparison with filters fabricated by
the conventional technology
13Victor N. Morozov | +7 (964) 567-68-63 | vmorozov@gmu.edu | fb.com/Nanofilters
Resistances to airflow of different electrospun
nanofilters having 99.97% collection
efficiencya for 0.3 µm aerosol particles at a
face velocity of 5 m/sec.
Filtering properties of Nylon nanomats,
manufactured by our and conventional
techniques.
Polymer ( span from solvent)
Knudsen number
(fibers diameter,
nm)
Pressure
dropb, Pa
OUR FILTER Nylon-4,6 (formic acid) [1] 6 (12) 29.5
Nylon-6 (formic acid) [2] 0.65-3.25 (20-100) 125.5
Nylon-6 (formic acid) [3] 0.69 (94) 224.4
Nylon-6 (formic acid) [4] 0.33 (200) 555
Polyurethanea (DMF) [5] 0.36 (180) 272.9
PLA (DCM 9%-DMAc 91%) [6] 0.24 (274) 111
HEPA[4] <0.1 (>650) >390
References
1. A.Y. Mikheev, Y.M. Shlyapnikov, I.L. Kanev, A.V. Avseenko, V.N.
Morozov, European Polymer Journal, 2016, 75, 317–328.
2. Y. Y. Kuo, F. C. Bruno, J. Wang, Aerosol Sci. Technol. 2014, 48, 1332–1344.
3. C. H. Hung, W. W. F. Leung, Sep. Purif. Technol. 2011, 79, 34–42.
4. Y. C. Ahn, S. K. Park, G. T. Kim, Y. J. Hwang, C. G. Lee, H. S. Shin, J. K. Lee,
Curr. Appl. Phys. 2006, 6, 1030–1035.
5. H. J. Choi, S. B. Kim, S. H. Kim, M. H. Lee, J. Air. Waste Manag. Assoc.
2014, 64, 322–329.
6. Z.Wang C. Zhao Z. Pan, J. Colloid and Interface Sci. 2015, 441, 121–129.
Notes to Table 1
aCollection efficiency for this filter was measured at a face velocity of 0.5 m/sec,
in all other cases at 5 m/sec.
bPressure drop on filters at a face velocity of 5 cm/sec.](https://image.slidesharecdn.com/nanofilters2017-170626075313/85/NANOFILTERS-13-320.jpg)